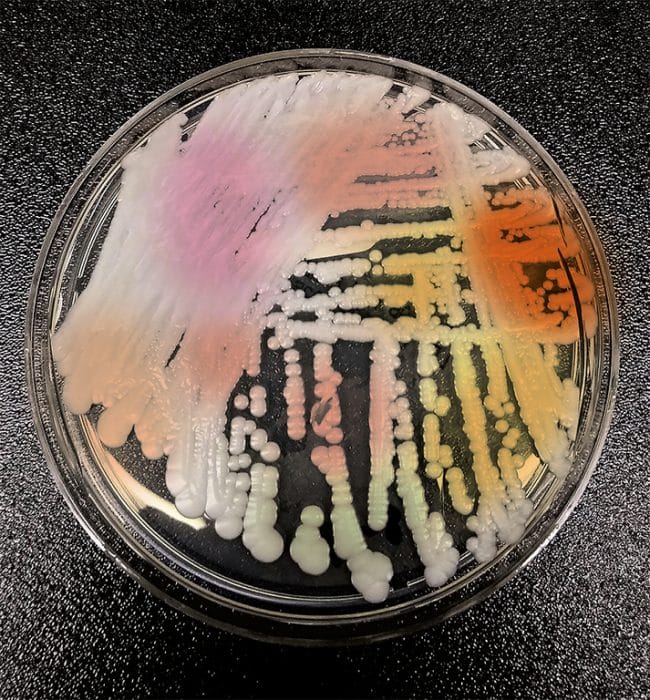

Photo: CDC
Le champignon microscopique Candida auris cause la pagaille dans les hôpitaux.
Une superbactérie ou une nouvelle souche de virus est souvent en cause lorsqu’il y a une épidémie. Mais depuis 2012, c’est plutôt la découverte d’une levure qui sème la pagaille dans les hôpitaux.
Le champignon microscopique, appelé Candida auris , a été trouvé dans l’oreille d’un malade japonais en 2009. Ce pathogène a ensuite été signalé dans 19 autres pays, dont le Canada, et continue d’entraîner des épidémies récurrentes aux États-Unis et au Royaume-Uni.
Habituellement, les levures occasionnent des infections bénignes, comme le muguet. Pas Candida auris . Opportuniste, il profite du système immunitaire déjà très affaibli d’un patient (d’où son statut d’infection nosocomiale, c’est-à-dire contractée à l’hôpital) en provoquant une infection grave. S’il s’introduit dans la circulation sanguine, le taux de mortalité qui lui est associé peut atteindre de 30 % à 60 %, selon une revue d’études publiée dans PLOS Pathogens en 2017.
La progression de cette « superlevure » inquiète les autorités sanitaires, d’autant plus que celle-ci demeure longtemps sur les surfaces et est très ardue à éliminer. Un hôpital londonien a été aux prises avec cette infection pendant 16 mois ; les 50 patients qui ont été touchés ont heureusement évité le pire. Mais l’hôpital a dû fermer son unité de soins intensifs durant deux semaines.








